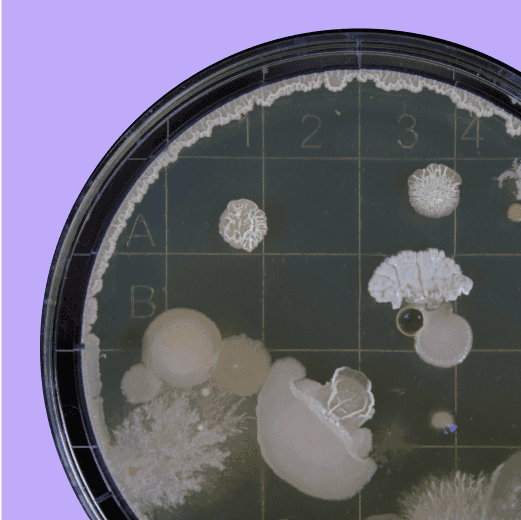

Our Funds
The simplest way to maximize the impact of your donations.

What are Founders Pledge Funds?
Our pooled philanthropic Funds direct money when and where it's needed most.
Each Fund is strategically focused on a cause area we’ve prioritized through extensive research, allowing you to support the causes you care about while tackling pressing problems.
Why choose a Fund?
Simplify your giving
Delegate decisions to dedicated grant-makers focused on maximizing impact, and access opportunities not available to individual givers. Your donation can power a portfolio of effective organizations and promising solutions. Funds are uniquely able to fill time-sensitive funding gaps, seed new initiatives, co-create and shape programs, and take advantage of innovative funding mechanisms.
How do Funds maximize impact?
- Funds fill urgent and time-sensitive gaps. When crises emerge or rare windows of opportunity open, the most impactful grants often need to happen fast. Most donors can’t mobilize quickly enough—but our Funds are built to move at the speed of need.
- Funds leverage deep domain expertise and networks. Most donors don’t have insider visibility into emerging opportunities. Our Fund teams do — they’re on the front lines of discovery, building relationships, attending closed-door convenings, and conducting rigorous research to surface the most promising interventions.
- Funds build diversified portfolios of promising opportunities. Strategic investors don’t put everything into one company—they spread their bets across different sectors and strategies to increase their odds of outsized returns. Similarly, our Funds enable you to adopt a portfolio approach to your giving.
- Funds create solutions that don't yet exist. Sometimes the highest-impact opportunity isn't funding what’s already there—it’s building something that’s missing. Our Fund Managers do active grantmaking to shape and launch projects that would otherwise never exist, filling gaps and blindspots in the current landscape.
- Funds unlock more resources through innovative funding mechanisms. Our Funds coordinate with other donors, run matching campaigns, and offer catalytic capital — approaches that amplify every dollar and reduce risk for individual donors.

▲ Photo by Herbert Goetsch on Unsplash
The Funds
Funds rapidly distribute money they receive. Every donation gets granted out to recipients, often within the year. Once made, a contribution to a Fund cannot be returned or transferred to another account.
The Funds are not investment vehicles and do not deliver investment returns to donors. The Patient Philanthropy Fund is an investment account, designed for long time horizons, but does not deliver returns to individuals.

Climate Fund
Make meaningful progress against climate change by funding the most effective and neglected solutions.
Global Catastrophic Risks
Reduce the greatest risks we face, and help protect every human being alive today and in the future.

GHD Catalytic Impact
Save and improve as many lives as possible with each dollar — create lasting change through catalytic giving.
Patient Philanthropy
Humanity's emergency fund. Safeguard and benefit our future by investing for the long-term.

Rapid Response
Filled critical, urgent funding gaps created by the USAID cuts, so high-impact organizations can continue delivering lifesaving interventions. Fund closed August 2025.
Maximize your impact
Contribute to a Fund
Founders Pledge members
You can easily contribute through your Donor Advised Fund (DAF) on our member app. If you don’t have a DAF set up or want to discuss your options, please reach out to your Community Manager.
You can direct any portion of your pledge to Funds; explore how they fit into your giving plans with our Advisors.
Not a member?
You can contribute to the Funds through every.org and Giving What We Can, or from any Donor Advised Fund. Please visit each Fund’s page for the exact links.
Fund Management
Our Funds are actively run by dedicated managers who are typically members of the Founders Pledge Research team.
Supporters of the Funds receive regular updates, including news about grants that are made, milestones and goals, and more detailed coverage of the work being done.
Grant-making
Granting decisions are made based on the existing fund balance and availability of high-impact grants. Grant recipients are chosen through careful evaluations, and are based on our research and each Fund’s unique strategy.
- Founders Pledge conducts original research on charities and cause areas. As full-time researchers, Fund managers know the numbers and evidence inside and out.
- We build networks in order to understand the philanthropic landscape and integrate ourselves into existing efforts.
- We consult external advisors, both domain experts and other charity evaluators, to source new opportunities and – just as importantly – to understand how our conclusions match up with the expert consensus on each cause area.
We accept and review requests for funding. Learn more and apply here.